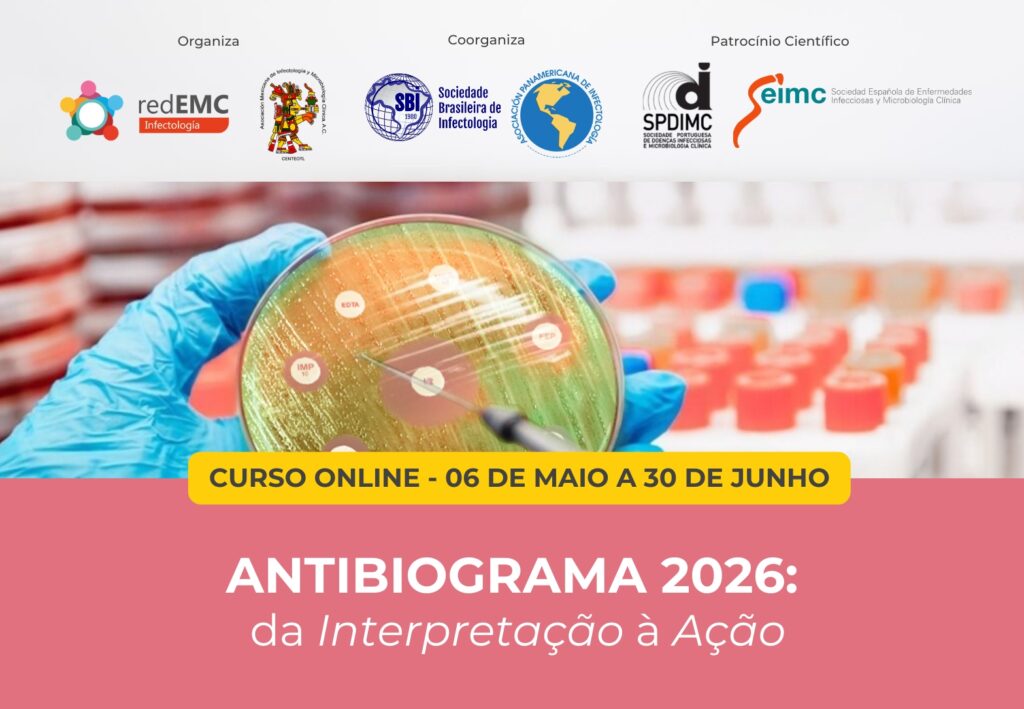

Cursos que inspiram mudanças
Cursos online para profissionais da saúde, com impacto na prática clínica diária. Faça parte da comunidade redEMC!


Este curso oferece uma oportunidade única para se atualizar com especialistas internacionais, dominar a leitura crítica do antibiograma e tomar decisões terapêuticas precisas diante dos desafios da multirresistência. Com uma abordagem prática, interdisciplinar e baseada em casos reais, este programa foi concebido para transformar o conhecimento em ação clínica eficaz.
Organizado pela Rede de Educação Médica Continuada para a Ibero-América (RedEMC) em conjunto com a Associação Mexicana de Infectologia e Microbiologia Clínica (AMIMC). Participam da coorganização a Sociedade Brasileira de Infectologia (SBI) e a Associação Pan-Americana de Infectologia (API).
Por consultas, escreva para soporte@redemc.net ou entre em contato pelo WhatsApp
Este curso lhe atualizará sobre os últimos avanços científicos em fisiopatologia, biomarcadores e mecanismos moleculares subjacentes às doenças glomerulares. Você aprenderá sobre novos tratamentos e terapias, como o uso da última geração de imunossupressores ou tratamentos biológicos, e será capaz de fazer diagnósticos mais precisos e precoces. Ao final do curso, você será capaz de identificar doenças glomerulares em seus estágios iniciais e melhorar a tomada de decisões clínicas para evitar complicações.
Organizado pela Rede de Educação Médica Continuada na Ibero-América (redEMC).
Cursos Flexíveis
Cadastre-se e comece quando quiser: materiais sempre disponíveis, cursos assíncronos e certificados
redEMC é a plataforma educacional que reúne tudo o você precisa para seu treinamento

Online
Cursos totalmente online e assíncronos, adaptados aos tempos dos profissionais e de curta duração com elevado impacto na prática clínica diária.
Bilíngue
Cursos em Português; com tradução aplicada a materiais acadêmicos e eventos presenciais, para um aprendizado integral.
Interativo
Nós nos conectamos com comunidades profissionais em toda a América Latina, através de fóruns de intercâmbio e atividades ao vivo.
Didático
Materiais didáticos e práticos elaborados exclusivamente por nossos profissionais para cada instância educacional.
Certificado
Apoiado pelas instituições organizadoras de cada atividade. Certificados com link verificável.
- +130 cursos realizados
- +30.000 Alunos
- +500 Professores
Temos trabalhado junto com
Somos a redEMC! Saiba mais sobre nós
?
redEMC, a Rede de Educação Médica Continuada, é a empresa líder na América Latina dedicada à educação médica com impacto na prática clínica.
Dispomos de uma equipe multidisciplinar qualificada, constituída por profissionais da área pedagógica, do setor médico, da área tecnológica, da área da comunicação e marketing digital, com vasta experiência na temática da educação médica continuada e com fortes ligações universitárias.
Trabalhamos em conjunto com importantes sociedades científicas da região e estabelecemos vínculos com sociedades internacionais para ministrar cursos de atualização com impacto na prática profissional.
Os cursos são ministrados em espanhol, português e/ou inglês; tudo com tradução para o idioma correspondente. Esse diferencial permite que os alunos ampliem suas redes e conheçam diferentes realidades e cenários sem limitações de idioma.
Todos os cursos contam com palestras gravadas, simulações virtuais, fóruns, webinars ao vivo, bibliografia complementar e certificado
Forjamos importantes laços acadêmicos entre diversos parceiros em toda a região, através do comprometimento e da excelência. Se você deseja fazer parte dos Parceiros Acadêmicos, convidamos você a nos escrever para administracion@evimed.net comentando sua proposta educacional e teremos prazer em lhe fornecer feedback.

Somos a Rede de Educação Médica Continuada para toda a América Latina. Somos especializados em soluções de e-learning na educação médica com impacto na prática clínica, juntamente com uma equipe de professores internacionais de alto nível.
Horário de atendimento ao público de segunda a sexta-feira, das 9h00 às 17h00 Uruguai (GMT-3)
📩 soporte@redemc.net
📲 WhatsApp +598 92 487 812